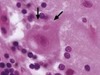

neuropath Flashcards
(38 cards)

Neuron. Large perikaryon; lots of nissl substance (RER), but abscent at axon hillock; large nucleus with prominant nucleolus and dispersed chromatin

Astrocyte. Glial cell; major function is to wrap foot processes around the basement membrane of blood vessels and non-synaptic parts of neurons–nutrient exchange; short and highly branched in gray matter, sparse and straighter in white matter.

astrocyte stained for GFAP
(cells around neuron)

oligodendrocytes; myelinate CNS; smalelr, rounder, darker nucleus than astro; 2-3 normally found around neuron (excess is perineuronal satellitosis)

ependymal cells. glial-derived epithelium lining ventricles and spinal canal. no basement membrane. absorptive/secretory/propulsive functions

choroid plexus. gilal-derived secretory epithelium; long microvilli with few cells. many mitochondria, golgi, and basal nuclei

red neurons. response to ischemic injury (12-24 hrs). shrunken soma, eosinophilia, loss of Nissl. nuclei often darker w/o nucleolus.

lipofuscin. normal age-related process of oxidized fatty acid accumulation. don’t confuse with SN, DMX, or locus ceruleus of rostral pons (pigmented areas)

flame-shaped cytoplasmic inclusions = neurofibrillary tangle in AD

Lewy Body inclusions

early abcess: PMN infiltration

late abcess: PMN debris surrounded by fibroblastic collagenous


Acid-fast stain shows TB organisms

microglial nodules (acute viral encephalitis)

intranuclear inclusions (acute viral encephalitis)

microglial nodule and neuronophagia (acute viral encephalitis)

perivascular infiltrate (actue viral encephalitis)

aseptic meningitis
Negri bodies (circumscribed eosinophilic cytoplasmic inclusions). Rabies

cysticercosis (taenia solium). from ingesting eggs. Parenchymal, meningeal, ventricular, spinal (rare) cysts

naegleria fowleri. Primary amebic encephalitis. Fulminant, acute meningoencephalitis with swelling, hemorrhagic necrossis of frontal lobes. Path: unicellular organisms with vesicular nucleus in subarachnoid space

zygomycosis (mucor). Classically DKA, rhinocerebral disease. wider, non-septate hyphae













